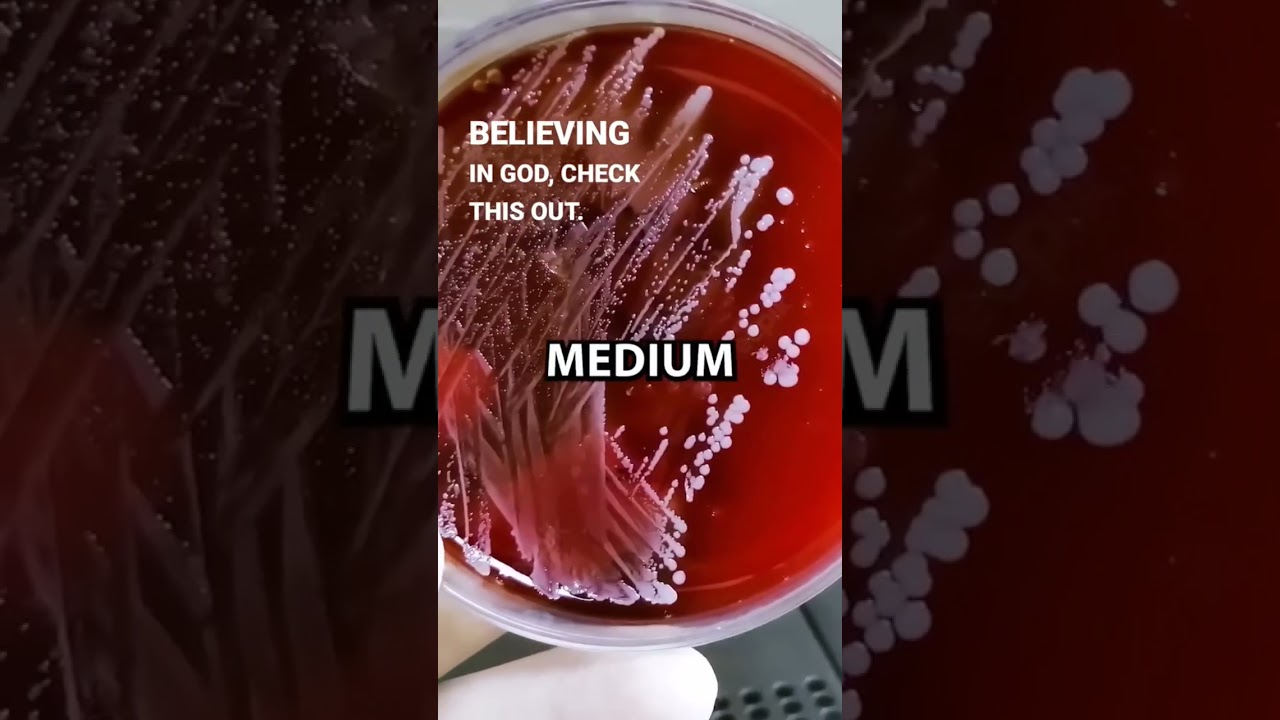
WATCH THIS IF YOU NEED PROOF 😱😱

WATCH THIS IF YOU NEED PROOF 😱😱
Повторяем попытку...

Доступные форматы для скачивания:
Скачать видео
-
Информация по загрузке:

Почки скажут вам: всего 1 стакан перед сном и ночные походы в туалет исчезнут | ПАМЯТЬ И МОЗГ

The Proof Is Out There: SUPERNATURAL HUMANS SURGE WITH ENERGY (Season 2) | Exclusive | History

Katastrofa samolotu z politykami / Pilne decyzje w Kremlu / Zawieszenie broni

Does Brain Science Disprove the Soul?

Nawet Tyson się go bał! Butterbean – najgroźniejszy nokauter wagi superciężkiej

EKIPA - TEMACIK (Friz, Wersow, Kostek)

Express Republiki 30.01.2026 | TV Republika

Археологи раскопали библейский Содом, то что нашли внутри шокировало, мурашки по коже

Квантовый ИИ закончил перевод запретной шумерской таблички — предупреждение пугает

WOJNA O KGHM. KROPIWNICKI UJAWNIŁ TAJEMNICĘ?

Ostatnie dni życia legendy zespołu Queen

Срочно! В США массово уб*вают и преследуют христиан.

13 островов, куда запрещено попадать до сих пор

"Nic tylko jechać na wakacje za granicę”. 1400 zł po 40 latach pracy

Свидетели Иеговы стучат в дверь пастора… и быстро уходят

Rosjanie o zmianach w ich życiu w ostatnich latach

ДНК Литвы: Они НЕ Славяне и НЕ Германцы! Страшная правда о происхождении Литовцев.

Брюс Ли был в спортзале, когда 136-килограммовый бодибилдер сказал ему: «Ты — одни кости» — спуст...

Coś zabija rosyjskich żołnierzy na froncie. I to nie jest Ukraina

В Туринской плащанице найден код ДНК, изучив его, ученые потеряли да речи…